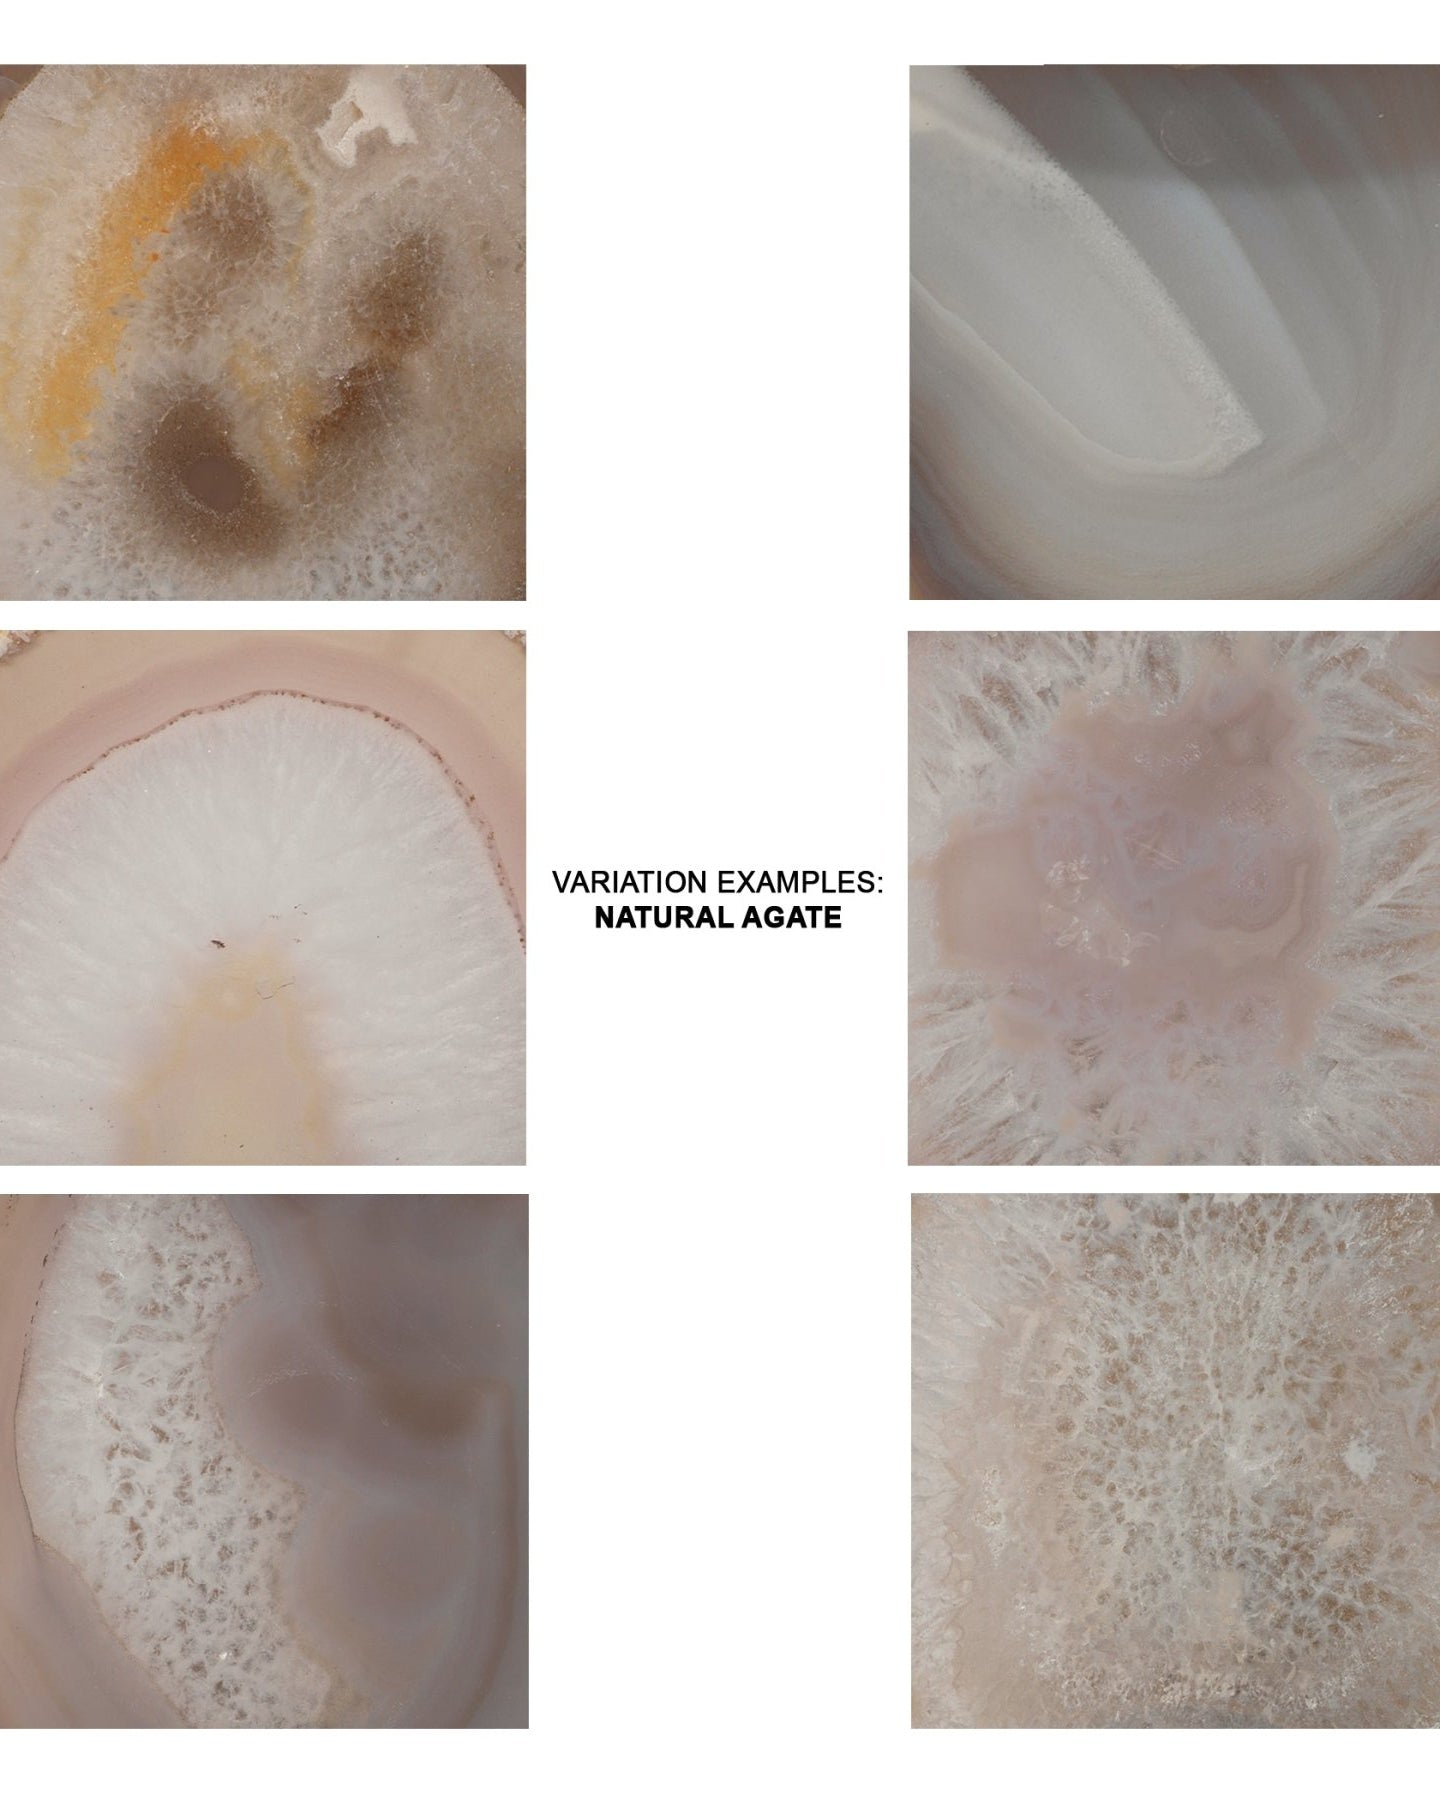
Trinity Wall Sconce - Marble Lotus - Trinity Wall Sconce

FAQs
What types of lighting fixtures do you offer?
We offer a wide range of lighting fixtures, including chandeliers, pendant lights, table lamps, floor lamps, wall sconces and indoor lighting.
How do I choose the right size chandelier for my room?
A general rule is to add the length and width of your room (in feet) to determine the diameter (in inches) of your chandelier.
For example, a 10x12 room would suit a chandelier with a 22-inch diameter.
How do I clean and maintain my lighting fixtures?
For regular maintenance, use a soft, dry cloth to dust your fixtures. Always avoid the use of harsh chemicals or abrasive cleaners as they may cause damage to the item's finish.
Do you have brass lamps?
Yes, we offer a variety of brass lamps, including table lamps, floor lamps, and wall sconces, in both polished and antique finishes.
What types of floor lamps do you offer with South Asian designs?
We offer a variety of floor lamps with gold and brass finishes that beautifully integrate modern design with traditional South Asian elements, adding warmth and cultural depth to any room.